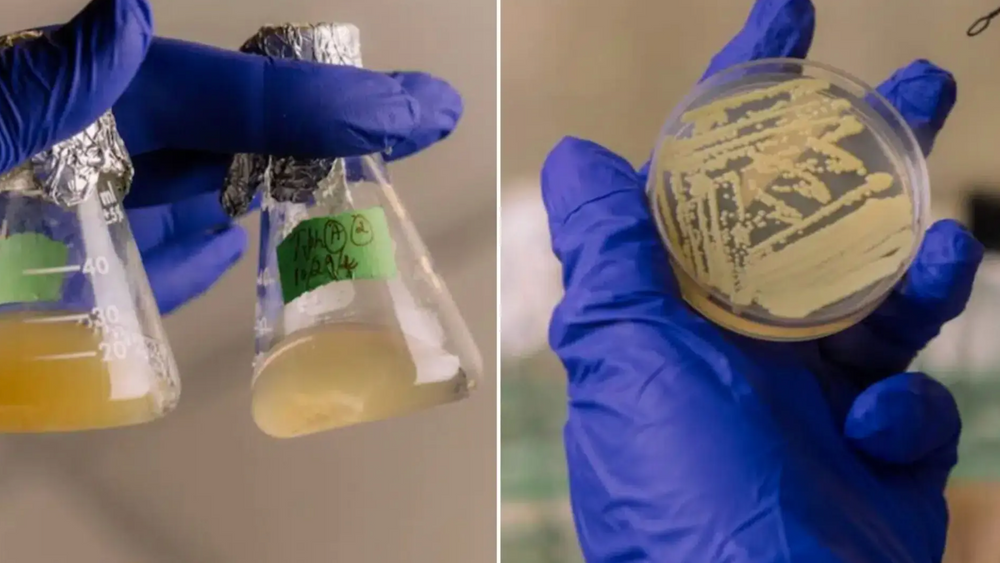
Bakterieartenromfart Tersicoccus phoenicis, som finnes i romfartøys renrom, kan overleve intensiv antimikrobiell rengjøring ved å «spille død».

Houston har faktisk oppdaget et problem.
Nasas renrom, der romfartøy på vei mot Mars settes sammen, kan huse uønskede blindpassasjerer. Forskere ved University of Houston har oppdaget at en bakterie som lever i disse ultrarene anleggene, i praksis kan spille død for å overleve brutale rengjøringsprosedyrer som ville drept de fleste andre livsformer.
Bakterien heter Tersicoccus phoenicis og ble først funnet på gulvet i et renrom for romfartøy ved Kennedy Space Center. Forskerne har nå vist at når denne mikroben utsettes for næringsmangel eller uttørking, går den inn i en tilstand der cellene fortsatt lever, men ikke vokser på dyrkningsplatene som brukes for å oppdage forurensning.
Etter bare to døgn med lufttørking sank den påvisbare bakteriepopulasjonen med mer enn 99,9999 prosent. Etter en uke kunne bare én til fire celler av millioner vekkes til live igjen med vanlige metoder. Men cellene var ikke døde. Da forskerne tilsatte et spesielt protein, RPF, i dyrkningsmediet, våknet bakteriene til liv igjen.
Ekstrem rengjøring
Denne evnen vekker bekymring. Romferder til destinasjoner som potensielt kan huse liv, må følge strenge protokoller for å unngå å forurense andre verdener.
Renrommene der romfartøy monteres, bruker ekstreme rengjøringsmetoder: Nøye kontrollerte temperaturer, filtrert luftsirkulasjon, begrenset luftfuktighet, kjemiske desinfeksjonsmidler og ultrafiolett stråling.
Til tross for disse tiltakene overlever enkelte mikroorganismer.
Hemmelig våpen
Det som gjør Tersicoccus phoenicis spesielt problematisk, er at den ikke danner sporer. Nasas deteksjonsmetoder er rettet mot sporedannende bakterier, noe som betyr at disse hvilende cellene kan slippe gjennom kontrollene.
Forskerne brukte derfor et protein kalt RPF fra en beslektet bakterie for å vekke de hvilende cellene. Med proteinet ble lagfasen – tiden før veksten starter – dramatisk forkortet, fra rundt 50–58 timer til 31 timer.


Tersicoccus phoenicis ser ut til å være nærmest spesialtilpasset for stresset i renrom. Den viste en millionfold reduksjon i dyrkbarhet etter 48 timers tørking, mens en nær slektning bare viste en tidobbel reduksjon.
Bakterien kan dessuten gå i dvale allerede etter 48 timer i rent vann, noe som viser hvor raskt den reagerer på ugunstige forhold.
Artikkelen ble først publisert på Ny Teknik

Ugelstadkulene: Den store, lille oppdagelsen